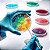
Triptona 500g Kasvi - Imagem 4

TRIPTONA FRASCO 500GR KASVI
A Triptona é uma digestão pancreática de caseína que contém todos os aminoácidos encontrados na caseína, bem como frações maiores de peptídeos. É utilizado para preparação de meios em que a caseína hidrolisada enzimática é desejada.
Especificações Técnicas:
Características Quimicas Especificações Análise Típica
Amino nitrogênio Mínimo 3,9% 4,20%
Nitrogênio Total Mínimo 10% 13,31%
Relação NA/TN N/A 31,70%
Perda da secagem Máximo 6% 3,30%
Cinza Máximo 15% 6,00 %
pH (solução 2%) 6,5 – 7,5 6,8
Armazenamento:
Armazenar entre 2°C a 25°C. Uma vez aberto manter o frasco do meio bem vedado e fechado para evitar a hidratação.
Registro ANVISA:
Produto não passível de registro na ANVISA.
Apresentação:
Frasco com 500 gramas.
Sinônimos: Tryptone.
- Nossos produtos são enviados em até 24 horas após a confirmação do pagamento.
- Os certificados de análise dos reagentes serão enviados por E-mail.
- Dados adicionais, como nº de projeto, nº pedido entre outros, poderão ser informados na nota bastando no momento da compra informar no campo adicional do pedido.
- Somos especializados em química fina, termômetros e densímetros e produtos para laboratórios.
- Nosso site possui certificação SSL e aqui você compra com 100% de segurança.
- Garantimos o envio mais ágil e os melhores preços.
Produtos relacionados
-
 Caldo Triptona De Soja (Tsb) 500g HimediaR$ 215,00até 3x de R$ 71,66 sem jurosou R$ 207,48 via Pix
Caldo Triptona De Soja (Tsb) 500g HimediaR$ 215,00até 3x de R$ 71,66 sem jurosou R$ 207,48 via Pix -
 Agar Triptona De Soja (Tsa) Frasco 500g Himedia
Agar Triptona De Soja (Tsa) Frasco 500g HimediaR$ 472,00R$ 429,00até 3x de R$ 143,00 sem jurosou R$ 413,98 via Pix9% Desconto
A Laderquímica atua há mais de 40 anos no mercado e é especializada na distribuição de produtos para laboratórios de controle de qualidade. Nossa linha é composta por Reagentes grau analítico, Meios de cultura, vidrarias especiais, termômetro e densímetro, equipamentos e frascos para coleta e armazenamento. Distribuímos as melhore marcas do Brasil e do mundo e garantimos excelente preços e prazo de entrega.